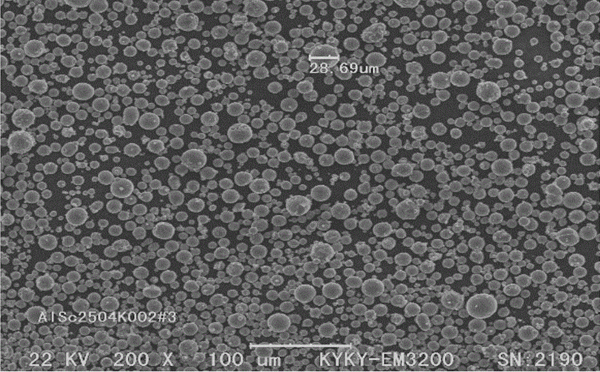
铝钪合金靶材金相图

铝钪合金靶材的组成主要是由铝、稀土和钪组成。铝作为基体元素,具有出色的力学性能和良好的导电性。稀土和钪则可以提高合金的力学性能和硬度。稀土铝钪合金靶材具有许多优异性能。首先,它的硬度非常高,可以轻松地达到维氏硬度0.8以下。其次,这种合金具有很好的耐腐蚀性,可以在高温、高压的环境下保持稳定的性能。此外,稀土铝钪合金靶材还具有很好的耐高温性,可以承受温度高达2000摄氏度的环境。
铝钪合金靶材特征
铝钪合金靶材形状:平面靶 异型定制
铝钪合金靶材纯度:3N
铝钪合金靶材尺寸:按图纸加工或者定制
我们还可以提供铝钪合金块、铝钪合金片、铝钪合金粉等

铝钪合金靶材的制备方法
熔炼,将铝原料和钪原料通过冷坩埚悬浮熔炼,得到铝钪合金铸锭,具体为:以钪原料和铝原料作为反应原料,首先将钪原料通过冷坩埚悬浮进行熔炼,得到钪熔体,再将铝原料分批次添加到钪熔体中熔炼,得到铝钪合金熔体;
将所述铝钪合金铸锭置于真空坩埚炉内,升温使铸锭熔融成为铝钪合金液,具体为:将所述铝钪合金铸锭置于真空坩埚内,将坩埚内的铸锭进行升温至1450~1650℃,升温的持续时间为25~35min,使坩埚内的铸锭熔融成为铝钪合金液后保温5~20min;
所述铝钪合金液进行雾化后得到铝钪合金粉末,具体为:将所述铝钪合金液通过雾化喷嘴流出与高速流动的气体相遇,雾化成为细小液滴,液滴在封闭的雾化室内凝固成铝钪合金粉末;
所述铝钪合金粉末进行烧结后得到铝钪合金靶坯,具体为:将所述铝钪合金粉末置于石墨模具中,再将石墨模具置于热压烧结炉内,升温升压至温度为950~1150℃、压力为20~40mpa,然后进行100~240min的恒温恒压,恒温恒压结束后撤去压力,使铝钪合金粉末冷却后得到铝钪合金粉末靶坯;
机加工,将烧结完成的模具取出,脱模,加工,即得到铝钪合金靶材,经测试靶材相对密度达到99%以上。
铝钪合金靶材应用
在航空航天领域,铝钪溅射靶材已用于飞机舱壁涂层、机翼涂层、各种旋转和运动齿轮以及燃料和排气系统。由于其低密度和高强度性能,铝钪合金产品在航空航天工业中潜力巨大;
在体育领域,铝钪合金用于制造棒球棒和高尔夫球杆等运动器材,铝钪溅射靶材用于头盔和运动金属设备的一些表面涂层;
在电子行业,铝钪合金以其密度低但强度高的突出特点,是电子产品外壳的首选产品。此外,使用铝钪靶涂覆其他材料的表面也提高了外壳的耐用性和寿命。除了电子外壳,铝钪合金溅射靶材还用于内部组件,例如涂覆半导体芯片和传感器。
铝钪合金应用
1.航空航天领域:铝钪合金具有高强度、低密度和高耐腐蚀性,因此广泛应用于航空航天工业,包括飞机和火箭的结构部件、发动机零件、航天器等。
2.汽车制造领域:铝钪合金可以用于汽车车身、底盘、发动机等部件的制造,提高汽车的性能、减轻汽车重量,并提高燃料效率。
3.建筑材料领域:铝钪合金可以用于制造高性能的建筑材料,如门窗、幕墙、梁柱、支架等,提高建筑物的强度、抗震性能和耐久性。
4.体育器材领域:铝钪合金的高强度、低密度和耐磨性使其成为制造体育器材的理想材料,如高尔夫球杆、棒球杆、滑雪板等。
5.电子和通讯领域:铝钪合金可以用于制造电子和通讯设备的外壳、内部结构以及一些高性能零件,如散热器、芯片载体等。
6.能源领域:铝钪合金可以用于制造太阳能电池板和风力发电设备等能源设备,提高设备的性能和使用寿命。